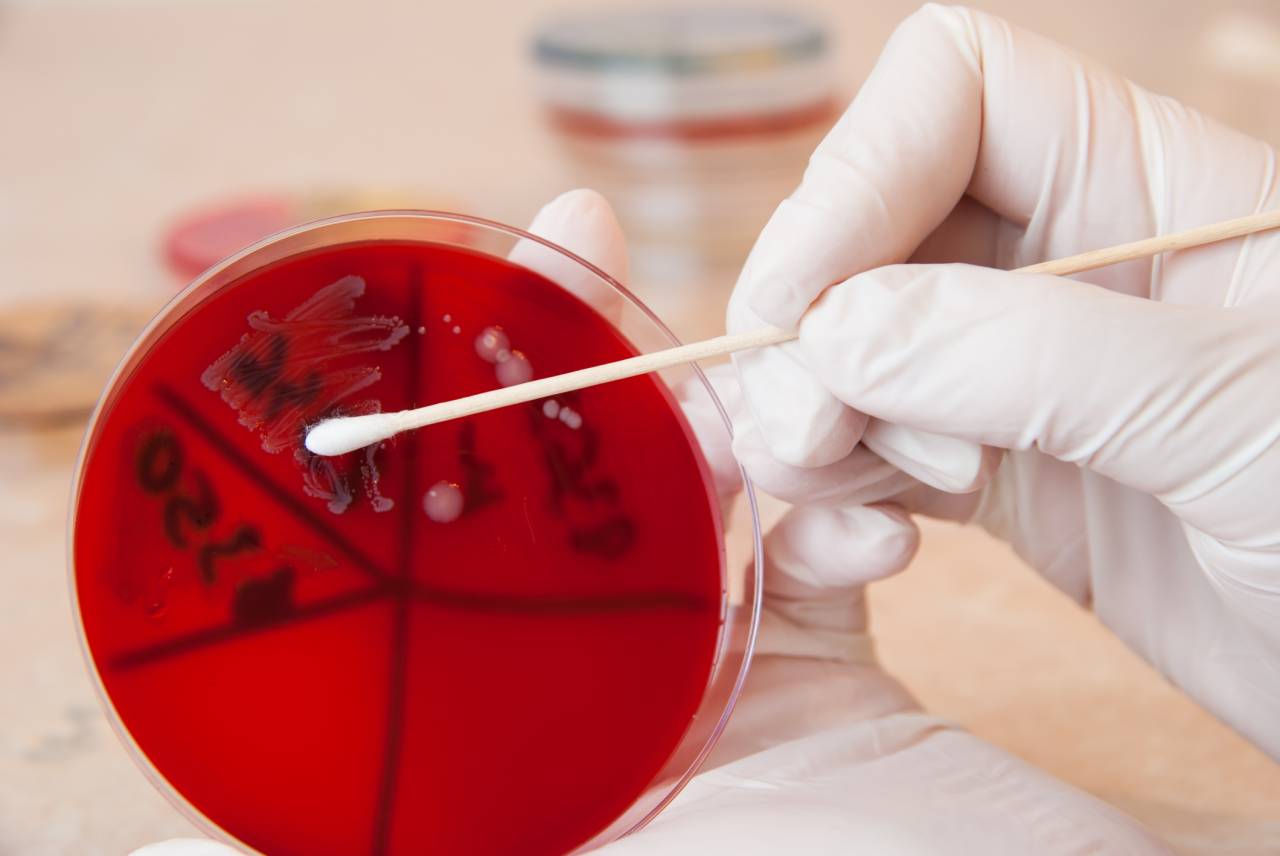

بكتيريا (تعبيريّة).
أثارت وفاة ابن الثلاث سنوات في تركيا جدلاً كبيراً، نتيجة تضارب التقارير الطبيّة بين المستشفى حيث تلقّى العلاج، والطبيب الذي وصف له علاجاً، بعد تشخيص إصابته ببكتيريا Strep A. وهي عدوى بكتيرية تُصيب الحلق والجلد، وتُسبب الحرارة والتهاب الحلق، وقد انتشرت أخيراً في العديد من الدول، فهل وصلت إلى تركيا؟!
وحسب وسائل الإعلام التركية المحلية، يدعى الطفل ي آراس سونماز ( Aras Sonmaz) وقد فارق الحياة في العاصمة أنقرة منذ أسبوعين بعدما أصيب ببكتيريا Strep A وفق ما أكد والده للإعلام.
لكن تقرير المستشفى، الذي نُقل إليه الطفل، لم يتوافق مع حديث الوالد، إذ جاء في التقرير الطبي أن "حالة الوفاة طبيعية، وتعود إلى انتشار لفيروس غامض في البلد". لكن الطبيب، الذي عاين الطفل، ووصف له العلاج، قال لوالده إن "طفله مصاب بعدوى بكتيرية".
أدّى التباين الطبيّ بين المستشفى والطبيب إلى جدل كبير في تركيا، وفق ما نشر موقع Time News.
أدّى التباين الطبيّ بين المستشفى والطبيب إلى جدل كبير في تركيا، وفق ما نشر موقع Time News.
وقد نُقل الطفل سونماز في بداية مرضه إلى مستشفى خاصّ في العاصمة أنقرة، حيث مكث لعدّة ساعات فقط، قبل أن يتمّ تشخيص إصابته بأنفلونزا موسميّة، مع الحديث عن إمكانية عودته إلى المنزل مع الأدوية العلاجية.
ولكن بعد ذلك، اضطرّ والده إلى نقل ابنه من جديد إلى المستشفى بعد أن ساءت حالته، قبل وفاته نتيجة إصابته بالعدوى البكتيرية، وهو ما ترفض المستشفى الاعتراف به.
ونتيجة الضجّة الكبيرة التي سبّبتها وفاة الطفل سونماز، أشار مسؤول تركيّ بارز في القطاع الصحيّ إلى أن "بكتيريا strep A انتشرت أخيراً في عدد من دول العالم، وظهرت في بريطانيا بعد سنوات على غيابها، ممّا أثار القلق عند هذه الدول، ولكن الأمر مختلف في تركيا".
من جهته، أكّد الأمين العام لـ"اتحاد أطباء تركيا" فيدات بولوت في حديث لـ"العربية نت" "أننا لا نعرف حتى الآن إذا كانت هذه البكتيريا قد انتشرت في تركيا أم لا، ولم تُدلِ وزارة الصحة بأيّ بيان حول هذا الموضوع، بالرغم من وفاة طفل يبلغ من العمر 3 سنوات، منذ أسبوعين، بعد إصابته ببكتيريا Strep A، ممّا يعني أن البكتيريا قد انتشرت بالفعل في تركيا".

وأضاف أن "وزارة الصحة لم تتّخذ أيّ إجراءات حتى الآن بشأن هذه البكتيريا. لكن من الضروري أن تُقدم الوزارة ومختلف المؤسّسات الطبيّة والصحيّة على خطواتٍ لسدّ الطريق أمام تفشّي هذه البكتيريا التي يتزايد انتشارها في الوقت الحالي في أوروبا. وستساعد الخطوات المتّخذة على إنقاذ المصابين والسيطرة على هذه البكتيريا في أسرع وقت ممكن".
ما هي هذه البكتيريا وكيف يمكن علاجها؟
المجموعة "ألف" من "الستريبتوكوك" (Streptococcus A) هي مجموعة من الجراثيم الموجودة عموماً على الجلد، وفي إفرازات الأنف واللعاب عند عدد كبير من الأشخاص، خصوصاً الأطفال والأولاد.
تنتج من هذه البكتيريا الالتهابات الروتينيّة:
* التهابات اللوزتين والحلق: ومن أهم أعراضها:
- ارتفاع في درجات الحرارة
- ألم في الحلق
- وجود التهابات على شكل تقيّحات بيضاء على اللوزتين.
* التهابات الجلد
وأهم أعراضها:
- احمرار
- سخونة وورم في الجلد في أيّ منطقة من الجسم
- تقرّحات أو بثور وخرّاجات.
*الإصابة بالالتهاب الرئوي (حالة نادرة): ومن أبرز أعراضه:
- ضيق في التنفس
- تسمّم حاد "شوك سيبتيك"
- التهاب العضل، ممّا قد يؤدي إلى البتر في بعض الحالات، وصولاً إلى الوفاة.
كيف يمكن تشخيصها؟
يمكن تشخيص مثل هذه الحالات من خلال فحص سريريّ وتأكيد مخبريّ بوساطة فحص الدم والأنسجة.
من هم الأكثر عرضة للإصابة بها؟
تصيب هذه البكتيريا الكبار والصغار، إلا أنّها شائعة أكثر عند الأولاد تحت سن الـ14، ونادراً ما تصبح خطرة عند الجميع.
طرق انتقال العدوى
تنتقل العدوى عبر اللعاب والإفرازات، ولتجنّبها يجب اعتماد:
* النظافة العامة،خصوصاً لجهة غسل اليدين المتكررّ بالصابون، وليس بالماء فقط.
* الابتعاد عن المريض، خصوصاً للفئات الأكثر عرضة للتأثر بهذه الجرثومة مثل الحوامل، والذين يخضعون للعلاجات الكيميائيّة وذوي المناعة الضعيفة، والجروح المفتوحة.
عادة ما تكون الالتهابات الناتجة من هذه الجرثومة بسيطة تطال الجلد والحلق. ولكن في بعض الحالات النادرة، يجتاح الالتهاب الحادّ العديد من الأعضاء الداخلية، ومنها الرئتان، حيث يؤدّي إلى الوفاة.
ما هو أفضل علاج؟
استعمال المضادات الحيويّة المناسبة قد يكون فعالاً، إذ يخفف من حدّة المرض، لكنّه لا يعطي مفعوله بالكامل فور تناوله، بل يحتاج إلى بعض الوقت، ونتائجه ليست مضمونة دائماً نظراً لوجود عوامل خطر أخرى، خصوصاً بكلّ جرثومة وكلّ مريض، وعلى الأخصّ في بعض الحالات من الالتهابات الحادّة جداً والنادرة، فلا تكون المضادات الحيويّة كافية نظراً لوجود أسباب أخرى معقّدة، مثل مشكلات المناعة أو الحالة الصحيّة العامة، أو الوضع الجيني للبكتيريا.
العلامات الدالة
الأكثر قراءة
المشرق-العربي
12/11/2025 6:15:00 AM
قذائف المزّة والعمليتان اللتان لم يفصل بينهما شهر تحمل رسائل تحذيرية إلى الشرع وحكومته، والرسالة الأبرز مفادها أن القصر الرئاسي تحت مرمى الصواريخ.
المشرق-العربي
12/11/2025 2:25:00 AM
إنّها المرة الأولى التي تتهم المنظمة "حماس" وفصائل أخرى بارتكاب جرائم ضد الانسانية.
المشرق-العربي
12/11/2025 2:10:00 PM
شدد على ضرورة منح المحافظة حكماً ذاتياً داخلياً أو نوعاً من الإدارة الذاتية ضمن سوريا كوسيلة لحماية الأقليات وحقوقها.
اقتصاد وأعمال
12/11/2025 10:44:00 AM
تكمن أهمية هذا المشروع في أنه يحاول الموازنة بين 3 عوامل متناقضة: حاجات المودعين لاستعادة ودائعهم بالدولار الحقيقي، قدرة الدولة والمصارف على التمويل، وضبط الفجوة المالية الهائلة التي تستنزف الاقتصاد
نبض